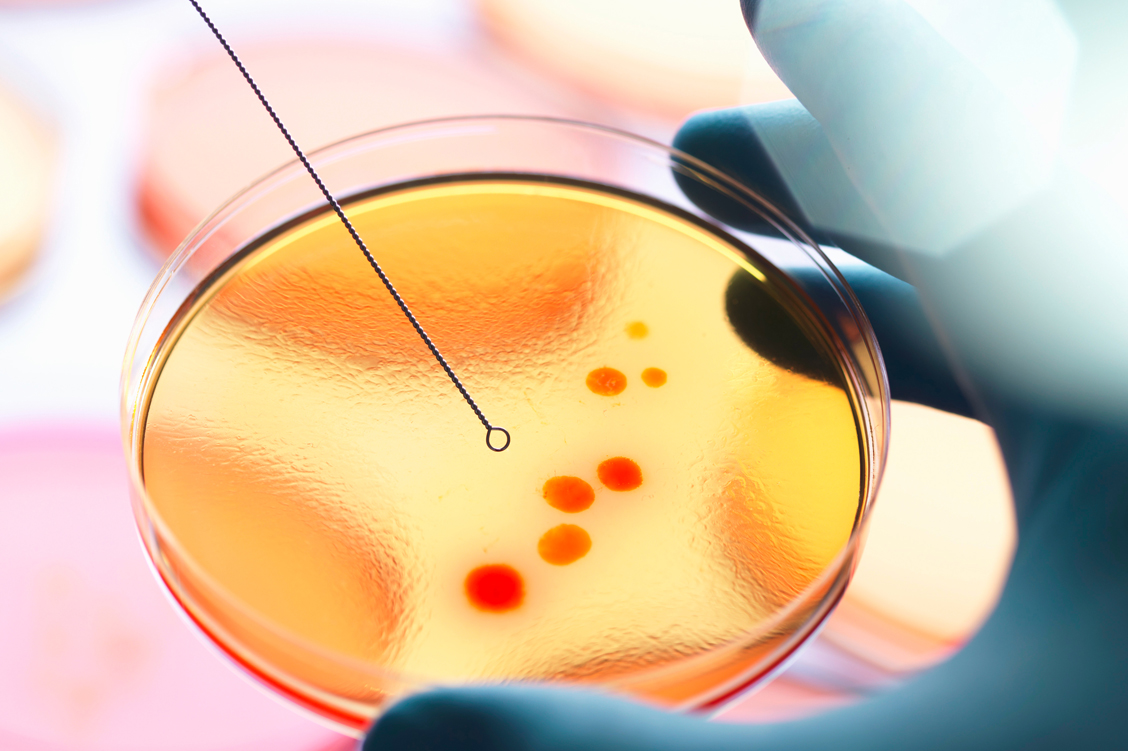

Die meisten neuen Antibiotika, die in den letzten Jahren auf den Markt kamen, wurden deshalb in dem Bestreben entwickelt, vorhandene Resistenzen zu überwinden. Zu den potenten Neueinführungen zählen beispielsweise die Cephalosporine Ceftarolinfosamil und Ceftobiprol, Tedizolid, ein Vertreter der Oxazolidinone, sowie das Glykopeptid Dalbavancin. Alle sind auch gegen MRSA wirksam.
Mindestens 20 weitere Kandidaten befinden sich aktuell in Phase-III-Studien beziehungsweise bereits im EU-Zulassungsverfahren. Darunter sind Mittel gegen Carbapenem-Resistenzen, MRSA, multiresistente gramnegative Keime sowie gegen multiresistente Tuberkulose-Erreger. Ziel der Antibiotikaforschung ist es, den Vorsprung der Medizin gegenüber den Resistenzentwicklungen der Bakterien zu wahren – im Idealfall sogar auszubauen. Denn die Erfahrung der vergangenen 90 Jahre seit der Entdeckung des Penicillins zeigt: Selten dauert es nach der Markteinführung eines neuen Antibiotikums länger als ein paar Jahre, bis sich Resistenzen dagegen entwickelt haben.